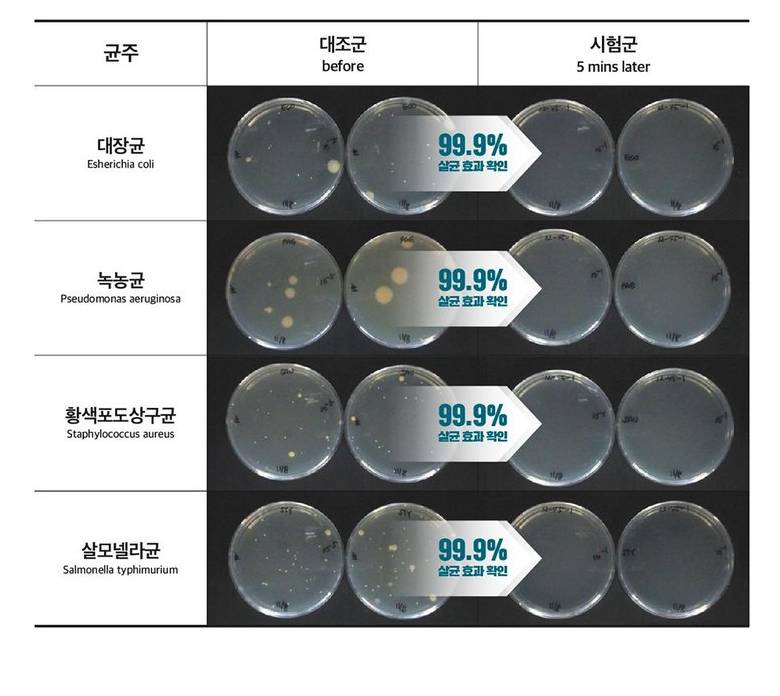

-38%
Lazy Society Razor Blade Cleaner, 120ml
Хэмнэлт:20,100
31,90052,000
Бүр төрлийн ирийг халдваргүйжүүлэх боломжтой ариутгагч шингэн цацлага. Хий ашиглаагүй тул хэрэглэхэд хялбар, аюул багатай ба бактери, нянг 99 хувь хүртэл устгаж, эвгүй үнэрийг дарна.
Хүргэлттэй
Бүтээгдэхүүний тайлбар